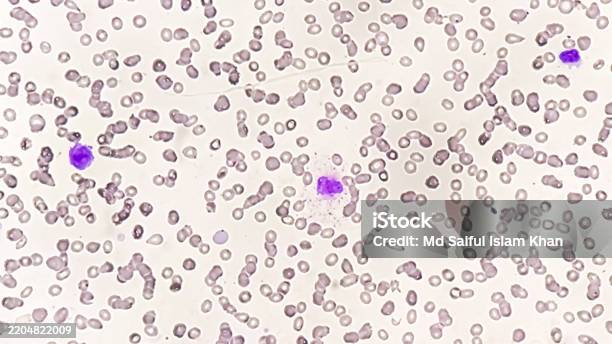

iStockPhotomicrograph Showing Marginal Zone Lymphoma With Thrombocytopenia A Rare Type Of Nonhodgkin Lymphoma Hình ảnh Sẵn có - Tải xuống Hình ảnh Ngay bây giờ
Tải xuống bức ảnh Photomicrograph Showing Marginal Zone Lymphoma With Thrombocytopenia A Rare Type Of Nonhodgkin Lymphoma này ngay bây giờ. Và tìm kiếm thêm trong thư viện hình ảnh sẵn có, trả phí bản quyền một lần của iStock có Bangladesh bức ảnh để tải xuống nhanh chóng và dễ dàng.Product #:gm2204822009$12.00iStockIn stock
Hình ảnh
Photomicrograph showing Marginal Zone Lymphoma with thrombocytopenia, a rare type of non-Hodgkin lymphoma bức ảnh sẵn có

Nh ững câu hỏi thường gặp
- Giấy phép trả phí bản quyền một lần là gì?
- Giấy phép trả phí bản quyền một lần cho phép bạn thanh toán một lần để sử dụng hình ảnh và đoạn video có bản quyền trong các dự án cá nhân và thương mại trên cơ sở liên tục mà không yêu cầu thanh toán bổ sung mỗi lần bạn sử dụng nội dung đó. Đó là cam kết đôi bên cùng có lợi và cũng là lý do tại sao mọi tài nguyên trên iStock đều sẵn có khi chỉ phải trả phí bản quyền một lần - bao gồm tất cả Bangladesh hình ảnh và cảnh quay.
- Những loại tệp tin trả phí bản quyền một lần nào có sẵn trên iStock?
- Giấy phép trả phí bản quyền một lần là lựa chọn tốt nhất cho bất kỳ ai cần sử dụng hình ảnh sẵn có cho mục đích thương mại, đó là lý do tại sao mọi tệp tin trên iStock - cho dù đó là bức ảnh, hình minh họa hay đoạn video - đều có sẵn mà chỉ phải trả phí bản quyền một lần.
- Tôi có thể sử dụng hình ảnh và đoạn video trả phí bản quyền một lần như thế nào?
- Từ quảng cáo trên phương tiện truyền thông mạng xã hội đến biển quảng cáo, bản trình bày PowerPoint đến phim điện ảnh, bạn có thể tự do sửa đổi, thay đổi kích thước và tùy chỉnh mọi tệp tin trên iStock - bao gồm tất cả Bangladesh hình ảnh và cảnh quay — phù hợp với các dự án của bạn. Ngoại trừ ảnh 'Chỉ sử dụng vào mục đích biên tập' (chỉ có thể được sử dụng trong các dự án biên tập và không thể sửa đổi), khả năng tùy chỉnh là vô hạn.
Tìm hiểu thêm về hình ảnh có trả phí bản quyền một lần hoặc xem Những câu hỏi thường gặp liên quan đến hình ảnh sẵn có.